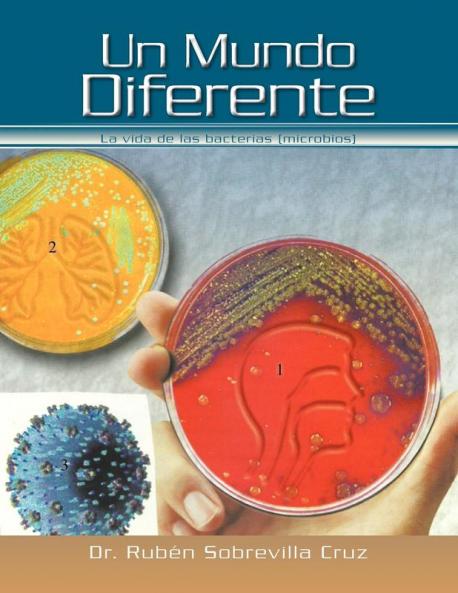
Un Mundo Diferente

Spanish
Paperback
₹1492
(All inclusive*)
Delivery Options
Please enter pincode to check delivery time.
*COD & Shipping Charges may apply on certain items.
Review final details at checkout.
Looking to place a bulk order? SUBMIT DETAILS
Delivery Options
Please enter pincode to check delivery time.
*COD & Shipping Charges may apply on certain items.
Review final details at checkout.
About The Book
Description
Author
Es Una Novela Cuento Que Señala La Vida De Las Bacterias (Microbios) A Diferentes Niveles Del Cuerpo Humano Constituyendo La Flora Normal Que Acompaña A Todas Las Personas. Por Medio De Cuento Trata De Elevar El Nivel Académico De La Población; Con Sus Imágenes Facilitará Al Niño Y Al Joven A Hacerlo Más Atractivo.
Details
ISBN 13
9781463314927
Publication Date
-27-12-2011
Pages
-42
Weight
-125 grams
Dimensions
-216x280x2.77 mm